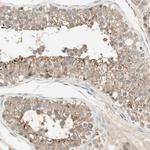
USP2 Antibody in Immunohistochemistry (Paraffin) (IHC (P))

Search
Invitrogen
USP2 Polyclonal Antibody
{{$productOrderCtrl.translations['antibody.pdp.commerceCard.promotion.promotions']}}
{{$productOrderCtrl.translations['antibody.pdp.commerceCard.promotion.viewpromo']}}
{{$productOrderCtrl.translations['antibody.pdp.commerceCard.promotion.promocode']}}: {{promo.promoCode}} {{promo.promoTitle}} {{promo.promoDescription}}. {{$productOrderCtrl.translations['antibody.pdp.commerceCard.promotion.learnmore']}}
产品信息
PA5-110723
种属反应
宿主/亚型
分类
类型
抗原
偶联物
形式
浓度
规格
纯化类型
保存液
内含物
保存条件
运输条件
RRID
产品详细信息
Immunogen sequence: SGFPYGVTNN CLSYLPINAY DQGVTLTQKL DSQSDLARDF SSLRTSDSYR IDPRNLGRSP MLARTRKELC TLQGLYQTAS CPEYLVDYLE NYGRKGSASQ VPSQAPPSRV PEIISPTYR
Highest antigen sequence indentity to the following orthologs: Rat - 77%, Mouse - 74%.
靶标信息
Ubiquitin is a highly conserved protein involved in the regulation of intracellular protein breakdown, cell cycle regulation, and stress response, is released from degraded proteins by disassembly of the polyubiquitin chains. The disassembly process is mediated by ubiquitin-specific proteases (USPs).
仅用于科研。不用于诊断过程。未经明确授权不得转售。
篇参考文献 (0)
生物信息学
蛋白别名: 41 kDa ubiquitin-specific protease; Deubiquitinating enzyme 2; similar to Gallus gallus ubiquitin-specific protease UBP41; Ubiquitin carboxyl-terminal hydrolase 2; ubiquitin specific protease 12; ubiquitin specific protease 9; Ubiquitin thioesterase 2; Ubiquitin-specific-processing protease 2; unnamed protein product; USP2b
基因别名: UBP41; USP2; USP9
UniProt ID: (Human) O75604
Entrez Gene ID: (Human) 9099